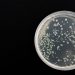
Hospitales de Edomex bajo vigilancia por bacteria Klebsiella oxytoca

Alrededor de las 7:30 horas de la mañana de este viernes se reportó una emboscada en contra de elementos de la Policía Estatal Preventiva de Sinaloa sobre la Calzada Aeropuerto, en Culiacán, con un saldo de ocho personas lesionadas.
Versiones preliminares destacan que la agresión ocurrió a la altura de la colonia Bachigualato, en las inmediaciones del Aeropuerto Internacional de Culiacán, cuando el convoy se acercaba al puente.
De acuerdo con los reportes, personas armadas que viajaban en un vehículo color tinto dispararon contra los agentes.
En redes sociales, vecinos de la colonia difundieron un video donde se escuchan las detonaciones.
Información preliminar refiere que el saldo fue de cuatro policías lesionados, así como cuatro civiles, tres hombres y una mujer, que fueron atendidos por personal de la Cruz Roja.
El sitio se encuentra acordonado por policías de distintas corporaciones, así como por elementos de la Secretaría de la Defensa Nacional (Defensa).
Hasta el momento ninguna dependencia ha emitido información oficial, pero se espera que en las próximas horas se amplíen los detalles.
Este suceso ocurre a 48 horas de la llegada a Sinaloa, del secretario de Seguridad Pública y Protección Ciudadana del Gobierno de México, Omar García Harfuch, para encabezar la estrategia contra la violencia que vive el estado desde el pasado mes de septiembre, con más de 500 homicidios reportados por las autoridades.
En la última semana, se han registrado decomisos históricos de fentanilo y detenciones de presuntos generadores de violencia en la entidad, también se ha registrado enfrentamientos y una serie de hallazgos de personas sin vida, de los que se espera una evaluación.
Mientras tanto, la presidenta de la República, Claudia Sheinbaum, defendió la estrategia de seguridad de su gobierno y aseguró que la estancia de García Harfuch en Culiacán es el mejor apoyo que el gobierno federal puede dar.
“El secretario de la SSPC está en Sinaloa para fortalecer la estrategia de seguridad. Ese es el mejor apoyo que se puede dar”.